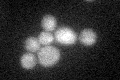
YKL087C

View description
Cytochrome c1 heme lyase, involved in maturation of cytochrome c1, which is a subunit of the mitochondrial ubiquinol-cytochrome-c reductase; links heme covalently to apocytochrome c1
Localization:
Intensity:
Fold change:
Significance:
-
C’ GFP library in SD
cytosol22.65 -
N' NOP1pr-GFP in SD

cytosol41.5649 -
N' TEF2pr-mCherry in SD

below threshold9.68067 -
N' NATIVEpr-GFP in SD

below threshold25.2119 -
N' TEF2pr-VC and Cyto-VN in SD

below threshold25.0181 -
C’ GFP library in SD+DTT

cytosol23.721.04No -
C’ GFP library in SD+H2O2

cytosol22.380.98No -
C’ GFP library in Starvation Media

cytosol23.271.02No -
C’ GFP library on the background of Pup2-DaMP

cytosol -
C’ GFP library on the background of CCT mutant

cytosol17.05750.752699No
